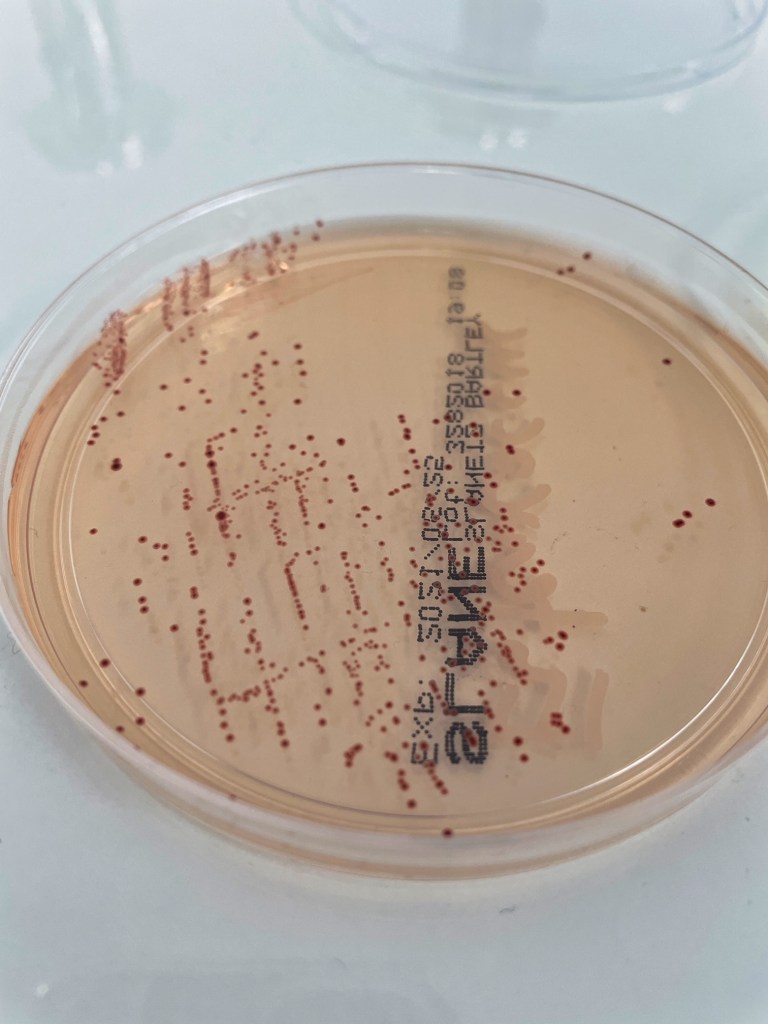
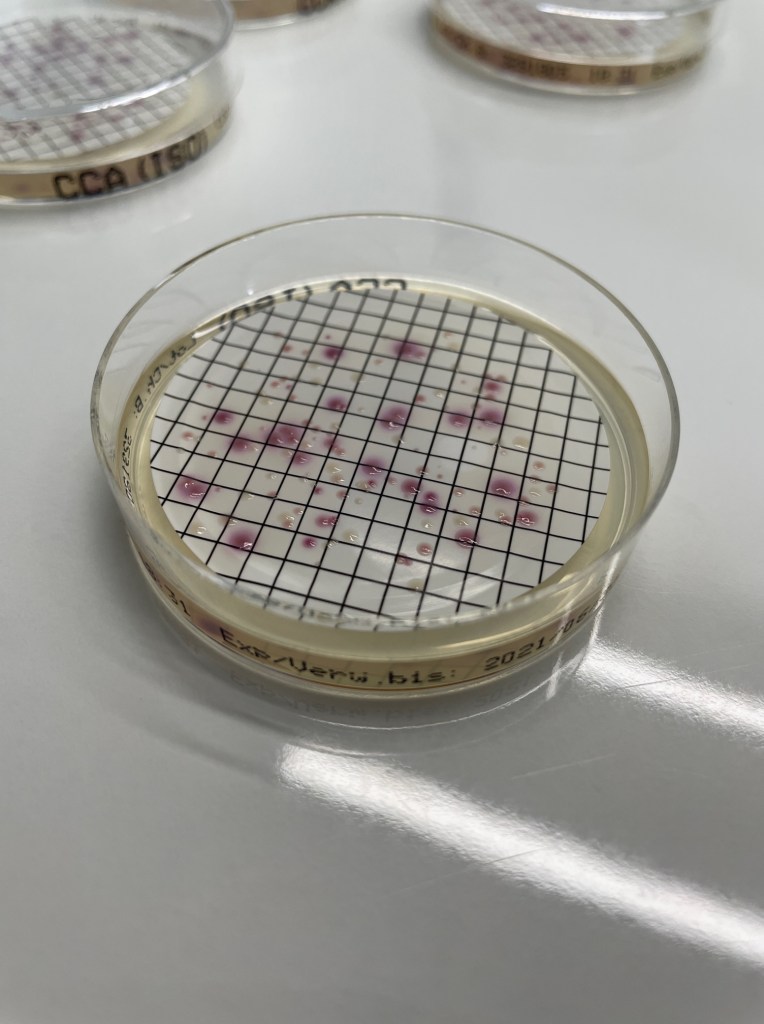
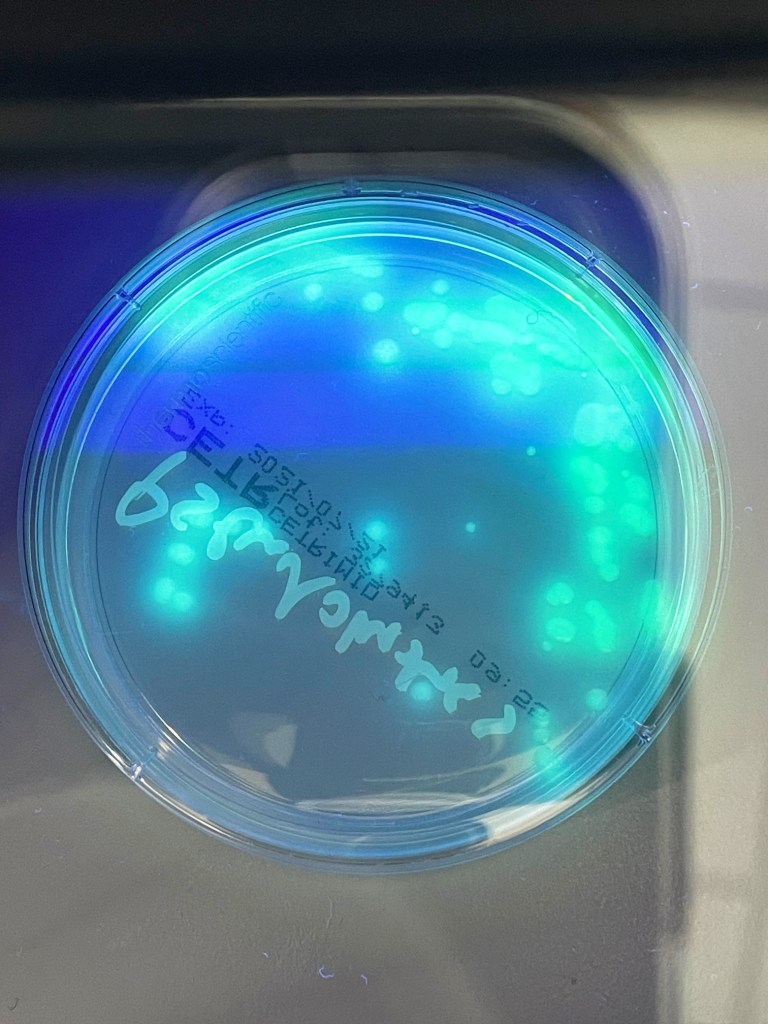

Trinkwasser ist nicht keimfrei. Auch nach sachgerechter Aufbereitung enthält es noch Mikroorganismen. Diese sind entweder harmlose Wasserbewohner oder Bakterien und Viren, die in den nach der Aufbereitung verbleibenden Konzentrationen keine gesundheitliche Bedeutung besitzen.
Umweltbundesamt, 2019
Mikrobiologische Überwachung der Trinkwasserqualität als akkreditierte Untersuchungsstelle
Um sicherzustellen, dass Bakterien und Viren nach der Aufbereitung des Wassers nur noch in gesundheitlich unbedenklicher Konzentration vorhanden sind, gibt es strenge mikrobiologisch-regulatorische Anforderungen zur Überwachung der Trinkwasserqualität. Diese Anforderungen basieren auf dem Infektionsschutzgesetz (IfSG) und der Trinkwasserverordnung (TrinkwV). Sie schreiben vor, dass Trinkwasser „keine Krankheitserreger in Konzentrationen enthalten darf, die die menschliche Gesundheit gefährden können“. (Umweltbundesamt, 2019)

Im Trinkwasser- und Badewasserbereich hat die Mikrobiologie eine hohe Bedeutung. Aufgrund der jahrzehnte lange Erfahrung unseres Teams im Bereich der Probenahme und der Arbeit im mikrobiologischen Labor, untersuchen wir Wasserproben gewissenhaft und mit großer Fachkompetenz.
Als akkreditiertes Prüflabor nach dem Standard der EN ISO 17025:2017 bieten wir mikrobiologische Untersuchungen an.